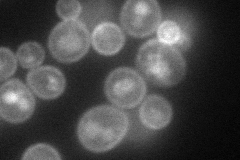
YMR011W
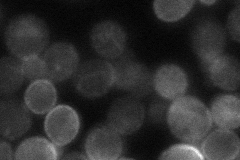
YMR011W
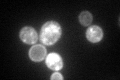
YMR011W

View description
High-affinity glucose transporter of the major facilitator superfamily, expression is induced by low levels of glucose and repressed by high levels of glucose
Localization:
Intensity:
Fold change:
Significance:
-
C’ GFP library in SD

cell periphery177.05 -
N' NOP1pr-GFP in SD
cell periphery,vacuole76.7686 -
N' TEF2pr-mCherry in SD

cell periphery,vacuole124.297 -
N' NATIVEpr-GFP in SD
cell periphery,cytosol41.7229 -
N' TEF2pr-VC and Cyto-VN in SD

cell periphery,punctate35.8446 -
C’ GFP library in SD+DTT

cell periphery202.221.14No -
C’ GFP library in SD+H2O2

cell periphery189.841.07No -
C’ GFP library in Starvation Media
punctate, cell peripheryN/AN/AYes -
C’ GFP library on the background of Pup2-DaMP

cell periphery -
C’ GFP library on the background of CCT mutant

cell periphery275.2511.55463Yes
